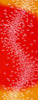

RIENZOME
Tenugui with Group of Dragonflies Pattern (839-R)
Tenugui with Group of Dragonflies Pattern (839-R)
Description
Group of Tonbo.
Tonbo - or Dragonflies have been a popular symbol in Japan ever since the Edo period. Being called "Kachi mushi" (winning flies), the pattern was often seen on the armor of samurai for good luck.
"Tenugui" is often translated as "Japanese towel", but this translation fails to cover their versatility and cultural significance. Tenugui are not only used as hand towels and handkerchiefs, but also function as fashion items, gift wrapping, souvenirs, sweat bands and padding (e.g. in the martial arts kendo), and of course as decorative items due to their often beautiful, funny or nostalgic patterns.
Please be aware that tenugui cloth by default never are hemmed, which allows them to dry very quickly.
Customers Also Viewed

Worldwide Shipping!

150 Years History!

8000+ Curated Items!

3000+ Reviews
PRE-SALES
If you have any questions before making a purchase chat with our online operators to get more information.
Ask An Expert or find our Questions & Answers